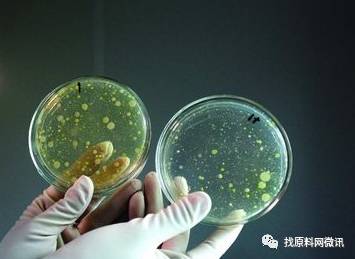

再不点蓝字关注,机会就要飞走了哦

今天跟大家分享一下化妆品实验室对一款产品的基本检验项目,希望能给初踏进这个行业的你带来帮助。
1
感官检验
外观、色泽:取样品在非阳光直射条件下进行目测
结果:外观无异物、均匀一致,色泽符合规定色泽则其项目为合格
香气:用辨香纸蘸取样品,用我们的嗅觉辨别
结果:香气符合规定香型,无异味。
2
理化检验
耐热试验
耐热试验是膏霜、乳液和液状化妆品重要的稳定性试验项目,如发乳、唇膏、润肤乳液、护发素、洗发水、洗面奶等产品均需进行耐热试验。
基本原理:
将电热恒温培养箱调节到(45±1)℃,取两份样品,将其中一份置于电热恒温培养箱保持24h后,取出,恢复室温后与另外一份样品进行比较,观察其是否变稀、变色、变味、分层及硬度变化等现象,判断产品的耐热性能。
结果:
与室温放置的样板一致,无异常则其项合格。
耐寒试验
同耐热试验一样,耐寒试验也是膏霜、乳液和液状等类产品的重要的稳定试验项目。
基本原理:
先将电冰箱调节到(-5~-15)℃±1℃,然后取两份样品,将其中一份置于电冰箱内保持24h后,取出,恢复室温后与另一份样品进行比较,观察其是否有变稀、变色、分层及硬度变化等现象,以判断产品的耐寒性能。
结果:
与室温放置的样板一致,无异常则其项合格。
离心试验
离心试验是检验乳液类化妆品货架寿命的试验,是加速分离试验的必要检验法,如洗面奶、润肤乳液、染发乳液等均需作离心试验。
方法:
在离心管中注入试样约2/3高度并装实,然后置于离心机中,以(2000-4000)r/min的转速试验30min后,观察产品的分离、分层状况。
结果:
无分层、出油均为合格。
pH值测定
人体皮肤的pH值一般都在4.5-6.5,偏酸性。
这是由于皮肤表面分有皮肤和汗液,其中含有乳酸、游离氨基酸、尿酸和脂肪酸等酸性物质。所以要求了化妆品一定的pH范围值,适合我们人体皮肤的需要,因此,pH值的测定是化妆品一项重要的性能指标。
测定方法:
直接用pH计进行pH值测定(粘稠液体或者膏霜乳液需预处理)。
结果:
符合行业标准或国家标准。
粘度测定
流体受外力作用流动时,在其分子间呈现的阻力称为粘度(或称粘性)。
粘度是流体的一个重要的物理特性,是膏霜类、乳液、洗涤类等化妆品的重要质量指标之一。
测试方法:
一般用旋转式粘度计测定。
结果:
达到产品内部粘度要求。
相对密度的测定
相对密度是指一定体积的物料质量与同体积水的质量之比。它是水剂化妆品的一项重要性能指标。
方法:
常用密度计法。
3
微生物的检验
化妆品中,特别是一些高级的护肤乳、膏等含有蛋白质、氨基酸、维生素以及各种植物的提取液等营养成分较高的物质,为霉菌、细菌等微生物的滋生、繁殖提供了良好的生长条件。
被微生物污染的化妆品,不仅影响产品本身的质量,而更严重的是它危及消费者的健康和安全。
因此世界各国极为重视,各国都制定了化妆品中微生物的卫生标准,将化妆品中微生物的污染状况作为产品的一个质量指标,以防止和控制微生物对化妆品的污染。
这对提高化妆品的质量和保证化妆品的安全性具有重要的意义。

化妆品主要针对菌落总数、霉菌和酵母菌总数来判断产品的污染情况。
上述就是实验室对产品的一个常规检验。
当然,不同的产品还有一些不同的检验项目;一款合格的产品,从原料、半成品、成品,每道工序都要经过严格的检验。
只有经得起实验验证的产品,才是一款合格的产品。
参考来源:
中国轻工业标准汇编《化妆品卷》(第四版)
【往期推荐】

更多精彩内容,回复关键字获取!
美白丨防腐丨彩妆丨防晒丨沐浴露
保湿丨天然丨抗衰老丨抗菌丨抗敏
激素丨皂基丨祛斑丨表面活性剂
配方丨工艺丨洗发丨香精丨祛痘
去屑丨行业观点丨行业动态
找原料网动态




